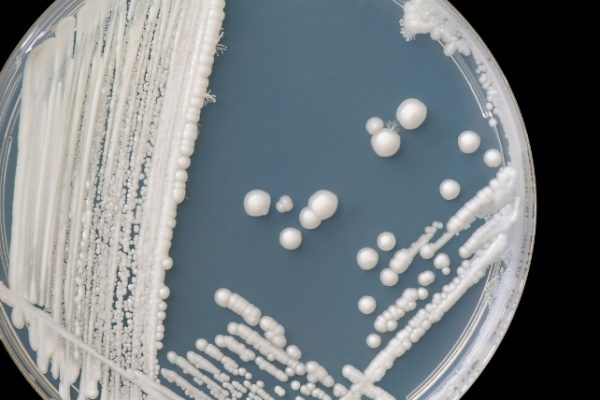

Terapia cu Microbiom ar Putea Ajuta Pacienții cu Melanom Rezistent la Medicamente
Terapia, cunoscută în prezent sub denumirea de MB097, este concepută pentru a fi administrată pacienților care nu au răspuns anterior la imunoterapie, în plus față de inhibitorul de punct de control pembrolizumab. MB097 a fost dezvoltat pentru a…